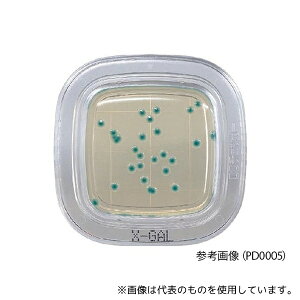
hw PD0005 ؂`FbNHDD X-GALV|n 1(20)

「pd」の人気商品一覧 | 安い商品を通販サイトから探す
13,030件 881〜920件を表示- 価格の安い順
- 価格の高い順
- 検索条件:
- 計測用具
- 本ページでは掲載するECサイトやメーカー等から購入実績などに基づいて手数料を受領しています。

その他の計測用具
納期・価格等ご注文前にお問い合わせください。 前澤化成工業 グリーストラップ 本体SUS製 GTS-PDオイル パイプ流入床吊タイプ ■機種 → GTS-3

その他の計測用具
《仕様》●pH・溶存酸素セット■セット内容:キャリングケース、メータ(WQ-320J)、pHセンサヘッド形式:300-P-2、pHカートリッジ形式:300-P-C、光学式DOセンサ形式:300-D-2、pH標準液(60ml):4.01...
この商品で絞り込む

その他の計測用具
日置電機(HIOKI) PD3129-10(KOUSEI) 検相器(メーカー校正書類付き/宛名記載なし)。【特長】●商品本体に、メーカーにて校正を行った校正証明書、検査成績書、トレサビリティ体系図がセットになった商品です...
![BV9820011 パナソニック 自動火災警報器用バッテリー NS鑑定品 24V 450mAh 20-S101A-PD [SOU]](https://www.denchiya.net/html/upload/save_image/BV9820011-01-xl.jpg)
計測用具
通常在庫あり!品番:BV9820011|メーカー:パナソニック|電圧容量:24V450mAh|形状:2H1V型(W型)|種別:自動火災報知設備用交換電池|ストック:通常在庫品|コネクター:統一コネクター|備考:20-S101A-PD ...

その他の計測用具
オイル阻集器(ガソリントラップ) 地中埋設専用 ステンレス製 パイプ流入式 3槽式 ■KS3-100PD+M20 本体 SUS304 バスケット SUS304 パンチングメタル マンホール蓋 鋼板製溶融亜鉛メッキ(T-20...
この商品で絞り込む
![■TAKEMOTO PD-0524Aポンプ(白)R150mmM〔品番:6091010003〕【7726147:0】[店頭受取不可]](https://tshop.r10s.jp/hcvalor-eshop/cabinet/trusco/7726/trusco-7726147.jpg?fitin=300:300)
その他の計測用具
《メーカー》竹本容器(株)《品番》6091010003《特長》●シンプルなデザインで幅広い用途にて使用されます。●適量吐出できる機能性ポンプです。《用途》《仕様》●幅(mm):28●奥行(mm):28●高さ(mm):196●名称:ポン...
![ホーザン HOZAN 【個人宅不可】 マイクロスコープ(PC用・PD-1付) L-KIT807A [42-210208]](https://img1.kakaku.k-img.com/images/category/search/loading.gif)
メジャー・巻尺
絞りをそれぞれ調節可能なズームレンズです。●大きさに加え高さもある観察対象や、作動距離を大きく取りたい場合におすすめです。◆用途◆仕様●倍率(倍):3.6〜100倍 ※24型ワイドモニター(解像度1920倍1080)使用時...
この商品で絞り込む

温湿度計
【アズワン AS ONE】実験室設備 工具類 工具、道具 商品の仕様 ●仕様:樹脂ケースセット ●バッテリー:14.4V(リチウムイオン5.0Ah) ●充電器:AC100V ●充電時間:実用充電/約40分 フル充電/約60分 ●回転数...

その他の計測用具
【アズワン AS ONE】分析・特殊機器 分離・分析ロシ クロマト用カラム、関連機器 ●柔軟性:積層構造により市販のフッ素チューブと比較して柔軟性に優れ、作業性が向上します。 ●ガスバリヤー性:内層の2フッ化系フッ素樹脂(PVDF系)...

その他の計測用具
【アズワン AS ONE】分析・特殊機器 培養機器・容器 培地等 商品の仕様 ●ブランド名:Petrislides ●主要アプリケーション:Environmental Analysis ●数量/箱:100 ●概要:PetriSlide...

その他の計測用具
【包括的な電力分析】: USB PD 3.1、EPR、AVS、TBT4、USB4に対応;多様なデバイス間での安定したパフォーマンス確認が可能;充電品質の詳細なモニタリングを実現 【高度なケーブル検出機能】: PD Eマーカ...

その他の計測用具
オイル阻集器(ガソリントラップ) 地中埋設専用 ステンレス製 パイプ流入式 3槽式 ■KS3-130PD+M02 本体 SUS304 バスケット SUS304 パンチングメタル マンホール蓋 鋼板製溶融亜鉛メッキ(T-2...
![ホーザン HOZAN 【個人宅不可】 マイクロスコープ(PC用・PD-1付) L-KIT801A [42-210222]](https://img1.kakaku.k-img.com/images/category/search/loading.gif)
メジャー・巻尺
●机などにクランプで取り付けるアームで、自由にカメラを固定したい場合におすすめです。●PD-1入組のマイクロスコープです。●PD-1をPCに接続することで、ホーザン製ソフトウェアの「CamPlus」の...
この商品で絞り込む

温湿度計
【アズワン AS ONE】実験室設備 工具類 工具、道具 ●電線の被覆の上からクリップするだけ ●矢印ランプ点灯(正相の場合)で、工事報告用の写真撮影が可能 ●LEDの回転表示により、三相電源の相順が一目でわかります ●正相時はピッピッと断
この商品で絞り込む

その他の計測用具
送料、代引手数料無料! 堀場製作所のフィールド型ポータブルpH・溶存酸素計D-210PDは、pHと溶存酸素が測定可能です。本体は2電極接続に対応しており、各電極を接続してモード切替ボタンで、pHとDOの同時測定が可能です。この商品は本...

計測用具
通常在庫あり!品番:BV9964011|メーカー:パナソニック|電圧容量:24V0.29Ah/5HR|ストック:取寄品|コネクター:統一コネクター|品名:20-AA290A-PD(古河電池)|種別:受信機用予備電源|品名:BV9964...
その他の計測用具
【アズワン AS ONE】分析・特殊機器 培養機器・容器 培地等 ●ぺたんと押して微生物チェックします。 ●特定の汚染菌の有無を選択的に確認できます。 ●一般細菌検出用培地は最短8時間で判定が可能です(発色液を使用)。 商品の仕様 ●...
この商品で絞り込む
![イマオコーポレーション ELESA エンプラダイアルインジケーター PD50R-1/30 [1525-060862]](https://img1.kakaku.k-img.com/images/category/search/loading.gif)
メジャー・巻尺
※メーカー確認後の出荷となります!確認後欠品・廃番等の問題が発生しましたらご連絡いたします!ご了承願います ◆特長●保護等級IP67採用。●シャフトの回転表示ができます。●窓(アクリル)と本体(ナイロン樹脂)は超音波溶接してあり、防滴...
この商品で絞り込む

その他の計測用具
【アズワン AS ONE】分析・特殊機器 分離・分析ロシ 分光光度計・原子吸光 ●アダプターを使用せずに角型・丸型キュベットが使用可能です。 ●少ない検体量(1.0mL)で測定が可能です。 ●ハロゲンランプの寿命は約2、000時間です...

温湿度計
【アズワン AS ONE】実験室設備 工具類 工具、道具 商品の仕様 ●差込線数:2 ●カラー:レッド ●入数:3個 ●定格:5A/100V ●適合電線:φ0.65・0.8mm φ0.9・1.2mm 【※ご注意ください】商品は代表の画...
![ホーザン HOZAN 【個人宅不可】 Counter ライセンスキー PD-2 [42-145029]](https://tshop.r10s.jp/daishinshop/cabinet/item/042-5/42-145029.jpg?fitin=300:300)
その他の計測用具
納期目安 (メーカーに在庫がある場合)13:30までにご注文の場合約3〜7日後出荷(土日祝日を除く)※表示の納期目安はあくまで目安ですのでお約束ではありません。具体的納期は都度お問い合わせください。お取り寄せ品です!ご注文後[商
この商品で絞り込む

その他の計測用具
オイル阻集器(ガソリントラップ) 地中埋設専用 ステンレス製 パイプ流入式 4槽式 ■KS4-380PD+F02 本体 SUS304 バスケット SUS304 パンチングメタル マンホール蓋 鋼板製防錆塗装(T-2...

その他の計測用具
特長 ●新定番USBカメラ × 定番ズームレンズ ●コンパクトサイズのベース(リング照明付) ●価格と性能を両立した300万画素USBカメラのセットです。 ●使い勝手のよいLEDリング照明付き。 ●レンズは倍率のみ調整可能なズームレン...
この商品で絞り込む
![■ヤマテック マルチパーツハンガー 片面タイプ 移動式 PD型 W1191×D574×H1480mm シルキーホワイト〔品番:MP1214CPD〕【6587690:0】[法人・事業所限定][外直送元][店頭受取不可]](https://tshop.r10s.jp/hcvalor-eshop/cabinet/trusco/6587/trusco-6587690.jpg?fitin=300:300)
その他の計測用具
《メーカー》山金工業(株)《品番》MP-1214C-PD《特長》●部材の取付位置・組み合わせ自由自在で多種多様な作業シーンに対応できる床置き式の工具部品整理棚です。●部材の取付高さは25mmピッチで調整可能なため...
この商品で絞り込む

その他の計測用具
商品の特徴 日置電機(HIOKI) PD3129(KOUSEI) 検相器(メーカー校正書類付き/宛名記載なし 【特長】 ●商品本体に、メーカーにて校正を行った校正証明書、検査成績書、トレサビリティ体系図がセットになった商品です...

その他の計測用具
型番102-0600204 商品説明【特長】●柔軟性に優れた積層型フッ素チューブで、従来のフッ素単層チューブに比べ、扱いやすく作業性が良好です。●内層がフッ素樹脂(2フッ化系)のため耐薬品性に優れ、ほとんどの薬品に耐性があります。(た

測量用品
光る矢印でより分かりやすく金属非接触で安全作業 矢印ランプ点灯(正相の場合)で、工事報告用の写真撮影が可能 LEDの回転表示により三相電源の相順が一目でわかります 正相時はピッピッと断続音、逆相時はピーと連続音でお知らせ 磁石がつい

その他の計測用具
納期・価格等ご注文前にお問い合わせください。 前澤化成工業 グリーストラップ 本体SUS製 GTS-PDオイル パイプ流入床吊タイプ ■機種 → GTS-3

その他の計測用具
■外付け圧力モジュール 750PD5の特長 ●圧力モジュールでの測定結果はデジタル出力ケーブルを介して表示器に表示 ●表示器にはフルーク圧力校正器と多機能校正器を全機種が対応 ...

その他の計測用具
光る矢印でより分かりやすく,金属非接触で安全作業 電線の被覆の上からクリップするだけ 矢印ランプ点灯(正相の場合)で、工事報告用の写真撮影が可能 LEDの回転表示により、三相電源の相順が一目でわかります 正相時はピッピッと断続音、

その他の計測用具
オイル阻集器(ガソリントラップ) 地中埋設専用 ステンレス製 パイプ流入式 3槽式 ■KS3-200PD+F20 本体 SUS304 バスケット SUS304 パンチングメタル マンホール蓋 鋼板製防錆塗装(T-20...
![■トーリハン 全自動防湿庫 ドライキャビ カメラ用PDシリーズ PD226W(6858624)[法人限定][外直送元]](https://tshop.r10s.jp/first34/cabinet/6858/trusco-6858624.jpg?fitin=300:300)
その他の計測用具
オレンジブック トラスコ中山 TRUSCOトーリハン 全自動防湿庫 ドライキャビ カメラ用PDシリーズ 〔品番:PD226W〕[ 注番:6858624]特長●マイコン制御による超エコ設計の高性能ペルチェ式除湿ユニットを搭載...

その他の計測用具
特長:光る矢印でよりわかりやすく、金属非接触で安全作業ができるワイドクリップタイプの検相器です。金属非接触のクリップで、電線の被覆の上からクリップするだけで安全に検相作業を行うことができます。矢印ランプで工事報告用の
![HIOKI 検相器 PD3129-10 [778-1342] 【電気測定器・テスタ】[PD312910]](https://tshop.r10s.jp/tatsumax/cabinet/02710737/keisoku/imgrc0072217398.jpg?fitin=300:300)
その他の計測用具
【特長】 ●金属非接触のクリップで、電線の被覆の上からクリップするだけで安全に検相作業を行うことができます。 ●LEDとブザー音で三相電源の相順を簡単に直感的に確認できます。 ●オートパワーオフ機能付です。 ●金属非接触のクリ

その他の計測用具
型番PD-2918-LL 商品説明【特長】 オフィスでも住宅でも使用できるデザイン。 Gx53フラットランプを使用し、実用的な机上照度確保しました。 ランプ交換型のため調光調色タイプへの変更も可能。 FHT24W相当...
この商品で絞り込む

その他の計測用具
型番102-0600404 商品説明【特長】●柔軟性に優れた積層型フッ素チューブで、従来のフッ素単層チューブに比べ、扱いやすく作業性が良好です。●内層がフッ素樹脂(2フッ化系)のため耐薬品性に優れ、ほとんどの薬品に耐性があります。(た

その他の計測用具
《仕様》●pH・溶存酸素セット■セット内容:キャリングケース、メータ(D-220PD)、pH電極:9652-20D、DO電極:9552-20D、pH標準液:pH 4.01、6.86、 9.18、取扱説明書/簡易マニュアル...
この商品で絞り込む
![BV98105011 パナソニック メーカー純正品 予備電源 自火報用バッテリー 24V1650mAh 20-S104A-PD 日本消防検定協会NS鑑定品 [SOU]](https://www.denchiya.net/html/upload/save_image/BV98105011-01-xl.jpg)
計測用具
品番:BV98105011|メーカー:パナソニック|電圧容量:24V1650mAh|ストック:取寄品|品名:BV98105011|種別:自動火災報知設備用予備電源|備考:古河電池 20-S104A-PD|その他:日本消防検定協会NS鑑...

その他の計測用具
デリケートな分銅の持ち運びと保管のためのケースです。 分銅の精密さ・美しさを保ち、安全に保管するアルミ製、木製、プラスチック製のケースを各種取り揃えております。 ※ 当該商品は自社販売と在庫を共有しているため、在庫更新のタイ

その他の計測用具
「はかる」技術を通じて「環境」「健康」「社会」に貢献します。

その他の計測用具
【アズワン AS ONE】物理・物性測定器 物性・物理量測定機器 物理、物性測定その他 ●材質:内部コンタクト:ベリリウム銅 ボディ:黄銅 ●メッキ仕様:コンタクト:金 ボディ:スズ ●適合オスピン径(φ):0.8〜1.0 ●オスピン...
この商品で絞り込む

その他の計測用具
特長 ●保護等級IP67採用。 ●シャフトの回転表示ができます。 ●窓(アクリル)と本体(ナイロン樹脂)は超音波溶接してあり、防滴性に優れています。 ●一回転させた時に長針は一回転して短針は1目盛進みます。 ●エンプラダイアルインジケ
この商品で絞り込む
![BV9963011 パナソニック 自火報用バッテリー 24V 225mAh 20-S201A-PD [SOU]](https://www.denchiya.net/html/upload/save_image/BV9963011-01-xl.jpg)
計測用具
通常在庫あり!品番:BV9963011|メーカー:パナソニック|電圧容量:24V225mAh|ストック:通常在庫品|品名:BV9963011|種別:自動火災報知設備用予備電源|備考:BV996301後継品|形状:2H1V型(W型)|コ...
その他の計測用具カテゴリで検索されているキーワード:
お探しの商品はみつかりましたか?
検索条件の変更
ご利用前にお読み下さい
- ※ ご購入の前には必ずショップで最新情報をご確認下さい
- ※ 「掲載情報のご利用にあたって」を必ずご確認ください
- ※ 掲載している価格やスペック・付属品・画像など全ての情報は、万全の保証をいたしかねます。あらかじめご了承ください。
- ※ 各ショップの価格や在庫状況は常に変動しています。購入を検討する場合は、最新の情報を必ずご確認下さい。
- ※ ご購入の前には必ずショップのWebサイトで価格・利用規定等をご確認下さい。
- ※ 掲載しているスペック情報は万全な保証をいたしかねます。実際に購入を検討する場合は、必ず各メーカーへご確認ください。
- ※ ご購入の前にネット通販の注意点をご一読ください。
- ※ 本ページでは掲載するECサイトやメーカー等から購入実績などに基づいて手数料を受領しています。
- pd
- DIY・工具
- 計測用具の通販情報・価格比較
- 価格.com
© Kakaku.com, Inc. All Rights Reserved. 無断転載禁止


